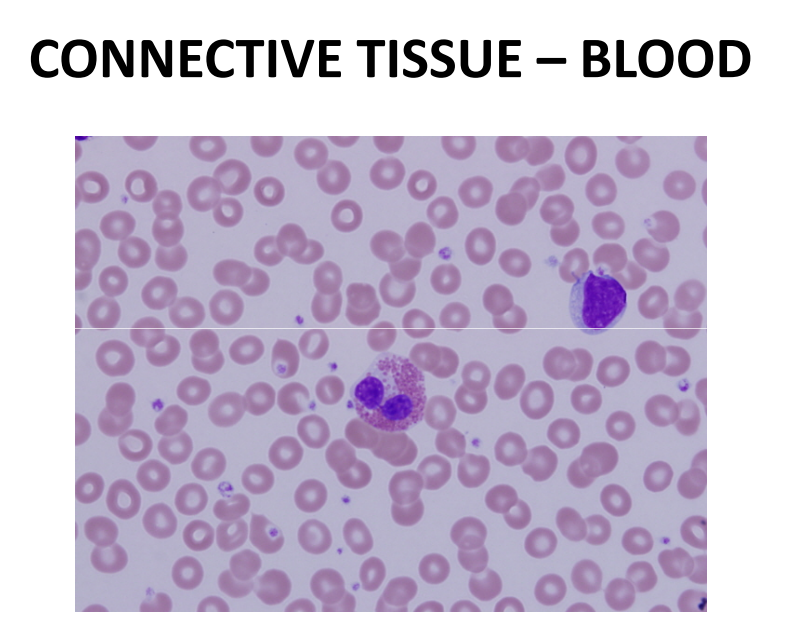

Epithelial

Simple Squamous Epithelium

Stratified squamous epithelium

Simple Cuboidal Epithelium

Simple Columnar Epithelium

Connective Tissue
Areolar Connective Tissue (Loose)

Reticular Connective Tissue (Loose)

Adipose Connective Tissue (Loose)

Hyaline Cartilage (Cartilage Connective Tissue)

Bone (Connective Tissue)

Blood (Connective Tissue)
Muscle Tissue
Skeletal Muscle

Cardiac Muscle

Smooth Muscle

Nervous Tissue
